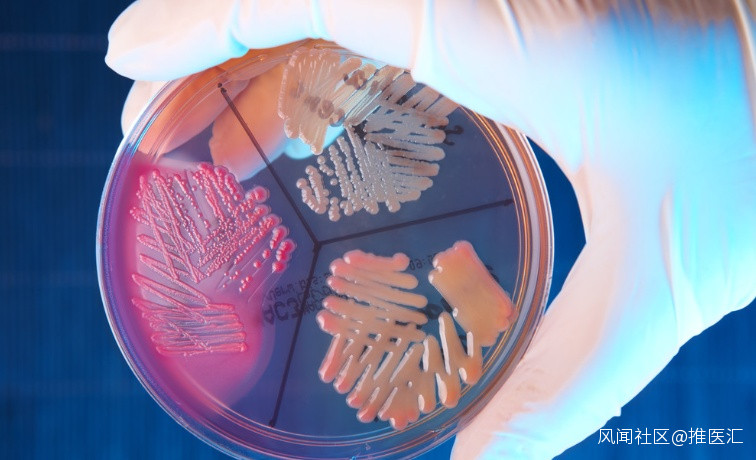

一塊冰西瓜送進搶救室,小心冰箱裏的細菌“殺手”,遠離“冰箱病”!_風聞
推医汇-汇聚健康行业资讯,推动学术交流。2022-08-04 16:40

前不久
杭州60歲的餘阿姨(化名)
卻因為吃了一塊冰西瓜
直接感染休克進醫院搶救
西瓜是好西瓜
那問題出在哪?
一塊冰西瓜送進搶救室
餘阿姨是杭州本地人,平時生活節儉,最近天氣炎熱,餘阿姨就挑了一個西瓜回家,由於家裏長年只有她和老伴兩個人,還特地挑了個水果店裏最小的西瓜。
一個西瓜,兩個老人切了放冰箱,吃了三天還有好幾塊。到第四天,餘阿姨的老伴打開冰箱打算扔掉西瓜,但節儉的餘阿姨捨不得,“四塊八一斤的西瓜,怎麼好扔掉呢,我來吃。”
西瓜進肚後,餘阿姨睡了個午覺起來感覺有點發冷,還以為是空調吹得有點着涼,到傍晚餘阿姨還出現了高燒、腹瀉等症狀,餘阿姨老伴以為她是吃冰西瓜導致的腸胃炎,還特地去藥店買了藥。
然而治療腸胃炎的藥好像沒什麼作用,折騰了一晚上,餘阿姨覺得兩眼發昏,雙腿發力,走路步子都跨不開了,去廁所的路上一頭栽在了地板上。
餘阿姨老伴急急忙忙叫了救護車送到了浙江大學醫學院附屬第一醫院。經過一系列檢查,餘阿姨已經出現了低血壓休克,體內的感染指標是正常值的幾千倍,這是已經是非常嚴重的細菌感染,並且已經感染性休克,隨時有生命危險,需要儘快搶救。
怎麼就休克了?
“醫生,我老伴平時身體很好的,就昨天吃了幾塊西瓜拉肚子,怎麼就突然要搶救了?”餘阿姨老伴簽着病危通知書的手都在抖,他百思不得其解好好的人怎麼突然就在搶救室了。
所幸,經過搶救與對症治療後,餘阿姨的生命體徵平穩,並轉入了感染病科接受進一步治療。
“您老伴是大腸埃希菌感染導致敗血症以及感染性休克。”浙大一院感染病科副主任醫師陳春雷博士向餘阿姨老伴解釋道,大腸埃希菌俗稱大腸桿菌,主要位於腸道中,這種菌是腸道的正常菌羣之一。但當如果大量攝入大腸桿菌中的某些致病菌株後就可能導致人體發病,那餘阿姨為什麼會感染大腸埃希菌呢?
“大腸埃希菌可以經口感染,長期不清潔的冰箱裏就可能存在這種菌。”陳春雷副主任醫師表示,長期不清潔的冰箱裏寄生着無數種細菌,如果食物不進行生熟分類存放,或者不用保鮮膜存放,那麼這些細菌就“串通一氣”,把食物污染個遍,再經過食物進口在人體內“興風作浪”。像大量大腸埃希菌經口進入人體內後,就可能突破人體胃腸道黏膜屏障,進入血中,嚴重時可引起肝膿腫、敗血症。
冰箱並非“保險箱”,這些細菌要小心

冰箱本身不具備滅菌功能,它的低温度環境抑制了多數微生物的生長繁殖速度,並抑制酶的作用來推遲食物的腐敗變質現象,然而嗜冷菌卻仍可繁殖,引起冷藏食物的腐敗。
嗜冷菌(psychrophile)是一類菌的總稱,這類菌一般在-15~20°C之間最適宜生長,由於這個温度段與其他菌最適宜生長的温度段相比要冷許多(普通細菌適宜生長温度為25~40°C),故此得名嗜冷菌。
嗜冷菌種最常見的為李斯特菌和耶爾森菌。

李斯特菌為兼性厭氧的革蘭氏陽性桿菌,產單核李斯特菌是最重要的種,這種細菌可以存活於多種不同的環境條件,在冰箱冷藏室4℃的條件下,就可持續生長繁殖,在0℃環境中也能緩慢生長,甚至在-20℃也可以存活長達1年。

耶爾森菌 中主要的是小腸結腸炎耶爾森菌,在冰箱冷藏室能存活和繁殖,其引起的腸炎,被稱為「冰箱腸炎」。
除嗜冷菌外,許多細菌在-10℃以下繁殖速度變慢,大約在冷凍庫-15℃時停止繁殖。不過,這並不代表細菌已經死了。一旦回到室温,細菌還是會大量繁殖,引起食物中毒。
冰箱中其他可以引起食物中毒的耐寒的菌包括:假單胞菌、大腸埃希菌、沙門菌、志賀菌和一些黴菌。
這些病原菌主要存在於乳製品、牛奶和一些肉類,尤其是牛肉、冰淇淋、沙拉、蔬菜中。我國近年來的食品安全風險監測結果顯示,產單核李斯特菌在生肉和即食食品中污染率最高。
如果誤食了被這些細菌污染的食物後,輕者出現腹痛、腹瀉、發熱等腸道疾病,嚴重的甚至招致敗血症及中樞神經系統感染。主要發生在孕婦、胎兒、新生兒、免疫力低下者及年長者。
避免冰箱細菌危害健康
最好做到以下幾點
1.
經常清潔冰箱:每月至少給冰箱清理一次。先把冰箱所有食物拿出來後,關閉製冷機,擦洗晾乾後通風半個小時,致病菌基本上就很難在冰箱裏面存活了。
2.
食物放對位置:冰箱裏囤積食物的種類越多、時間越長,冰箱裏的“殺手”就越多。冰箱內食物最好不要超過7成滿,以利於冷空氣流通,確保温度達標。牛奶最好購買一次性食用量,如實在食用不完,建議不要再次儲存。橙汁等飲料開封后蓋嚴再冷藏,一般不要超過48小時。
3.
生熟分開:生食中普遍都存在有各種寄生蟲以及細菌,和熟食放在一起會污染了熟食。生肉冷藏最多放3-5天,生的海鮮類則最多放1-2天。熟的放在上面,生的放在下面,飯菜、熟食等從冰箱取出後需充分加熱後再食用。
4.
生食處理後再放入冰箱:在購買魚肉、豬肉、牛肉等食物時,最好是能進行相應的處理後,再放入冰箱。像鮮魚、肉等食物最好是先用塑料袋密封,再放入冷凍室貯藏。而蔬菜、水果則要把外表的水分擦乾,再放入冰箱,貯藏在4℃以下的環境中為宜。
5.
注意食物的冷藏時間:如煮熟的雞蛋冷藏週期是一個禮拜左右;牛奶在5天左右;酸奶建議最長10天;切開的西瓜、楊梅等難以存放的水果儘量不要超過24小時。超過冷藏時間的食品,建議不要再食用,且一定要及時處理,因為腐敗變質的水果更容易滋生細菌,導致冰箱裏細菌更多。
6.
剩飯剩菜須徹底加熱:吃剩下的飯菜,第一時間用保鮮膜包住,放在冷藏室。葷菜最多保存2-3天,素菜最多保存48小時,涼拌菜建議當下吃完。冰箱冷藏過的剩菜剩飯應該加熱後食用,一定要熱透,且不要反覆加熱剩菜,剩菜應該下一次全部吃完。
五步還你一個乾淨冰箱
想擁有一個乾淨的冰箱
建議每個月進行徹底清理一次

第一步清空冰箱
給冰箱做清潔前,要先切斷電源,還要將冰箱內的所有食物都拿出來。然後將冰箱內的擱架、果蔬盒等取出來,用洗潔精清洗乾淨,放在一旁晾乾。
第二步自然解凍冷藏櫃
不要用尖鋭的物品剷除冷藏櫃裏的冰塊,也不要用熱毛巾敷,這樣容易導致冰箱故障。
第三步內外分別擦乾淨
清洗完冰箱內部,將門敞開,讓它自然風乾,然後,擦拭冰箱外部。有油漬或污垢的地方,可以用牙刷蘸着洗潔精輕刷,再用軟抹布擦乾。
第四步清潔死角別放過
冰箱背面的通風柵,要用軟毛刷清理,再用乾燥軟布擦乾。需要注意的是,冰箱門上的密封條是清潔死角,上面的微生物可達20多種,最好用酒精浸過的軟布擦拭。
第五步活性炭包除異味
活性炭有吸附有害物質的作用,也可以去除冰箱內的異味,尤其是剩飯剩菜的味道。雙門冰箱內放一個小型炭包,三門或多門冰箱可以多放置幾個。